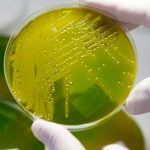
Crean bacteria fluorescente para detectar minas antipersonales

Etiqueta: bacteria
Indira Rojas se contagia de peligrosa bacteria en un restaurante de Nicaragua
La presentadora y ex reina de belleza en Nicaragua, Indira Rojas, sorprendió a sus seguidores en redes sociales con una denuncia pública en donde...
Nanotecnología para superar la resistencia a los antibióticos
Madrid, 4 oct (EFE).- El uso de nanopartículas activadas por la luz -llamadas puntos cuánticos- puede dar un impulso crucial a la eficacia de...
Identifican nuevo antibiótico contra la gonorrea multirresistente
Hay una nueva arma contra la gonorrea multirresistente. Se trata de un nuevo antibiótico que ha demostrado ser efectivo contra las cepas multirresistentes de...
Presencia de bacteria chlamydia aumenta 10 veces la posibilidad de abortos
México, 31 jul (EFE).- La presencia de la bacteria chlamydia puede incrementar hasta 10 veces la posibilidad de sufrir un aborto, según una investigación...
Jamón crudo, el secreto alimenticio para combatir una bacteria fatal
El jamón crudo es, sin dudas, uno de los alimentos preferidos a nivel mundial. Pero científicos de España y de Argentina fueron más allá...
Elton John contrajo una infección «potencialmente mortal» tras la gira en Sudamérica
El músico pop británico Elton John se recupera tras padecer una infección "potencialmente mortal" contraída al término de una gira en Sudamérica, estuvo internado...
Crean bacteria fluorescente para detectar minas antipersonales
Científicos en Israel lograron desarrollar una técnica con una bacteria fluorescente para detectar minas antipersonales y diferentes tipos de municiones que se encuentren enterradas, según un...
Mueren 2 menores en Panamá por enfermedad que transmiten las garrapatas
Panamá, 29 mar (EFE).- Las autoridades sanitarias de Panamá confirmaron hoy la muerte de dos menores por rickettsiosis, una enfermedad que transmiten las garrapatas...
OPS: La tuberculosis sigue siendo un problema asociado a la pobreza
La tuberculosis "siendo un problema de salud pública asociado a la pobreza" y afecta principalmente a personas con VIH y habitantes de barrios marginales,...